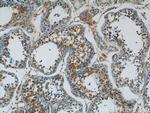
ARCN1 Antibody in Immunohistochemistry (Paraffin) (IHC (P))

Search
Proteintech
ARCN1 Polyclonal Antibody
{{$productOrderCtrl.translations['antibody.pdp.commerceCard.promotion.promotions']}}
{{$productOrderCtrl.translations['antibody.pdp.commerceCard.promotion.viewpromo']}}
{{$productOrderCtrl.translations['antibody.pdp.commerceCard.promotion.promocode']}}: {{promo.promoCode}} {{promo.promoTitle}} {{promo.promoDescription}}. {{$productOrderCtrl.translations['antibody.pdp.commerceCard.promotion.learnmore']}}
产品信息
23843-1-AP
种属反应
宿主/亚型
分类
类型
抗原
偶联物
形式
浓度
规格
纯化类型
保存液
内含物
保存条件
运输条件
产品详细信息
Immunogen sequence: KELQQARRD AERQGKKAPG FGGFGSSAVS GGSTAAMITE TIIETDKPKV APAPARPSGP SKALKLGAKG KEVDNFVDKL KSEGETIMSS SMGKRTSEAT KMHAPPINME SVHMKIEEKI TLTCGRDGGL QNMELHGMIM LRISDDKYGR IRLHVENEDK KGVQLQTHPN VDKKLFTAES LIGLKNPEKS FPVNSDVGVL KWRLQTTEES FIPLTINCWP SESGNGCDVN IEYELQEDNL ELNDVVITIP LPSGVGAPVI GEIDGEYRHD SRRNTLEWCL PVIDAKNKSG SLEFSIAGQP NDFFPVQVSF VSKKNYCNIQ VTKVTQVDGN SPVRFSTETT FLVDKYEIL (164-511 aa encoded by BC093636)
靶标信息
This gene maps in a region, which include the mixed lineage leukemia and Friend leukemia virus integration 1 genes, where multiple disease-associated chromosome translocations occur. It is an intracellular protein. Archain sequences are well conserved among eukaryotes and this protein may play a fundamental role in eukaryotic cell biology. It has similarities to heat shock proteins and clathrin-associated proteins, and may be involved in vesicle structure or trafficking.
仅用于科研。不用于诊断过程。未经明确授权不得转售。
生物信息学
蛋白别名: Archain; archain vesicle transport protein 1; coatomer delta subunit; coatomer delta-COP; coatomer protein complex, subunit delta; coatomer protein delta-COP; Coatomer subunit delta; COPI coat complex subunit delta; Delta-coat protein; Delta-COP; pale coat neuro; unnamed protein product
基因别名: 4632432M07Rik; ARCN1; COPD; nur17; SRMMD; SSMG
UniProt ID: (Human) P48444, (Mouse) Q5XJY5
Entrez Gene ID: (Human) 372, (Mouse) 213827